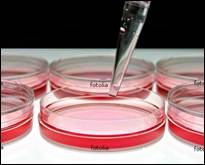
财富

生物设计培训
带着问题,布莱恩·费伊(Brian Fahey)几乎走遍了斯坦福大学医院所有的科室和手术室,他的搜寻范围似乎是无限的。在这段时间里,他观察到大量戴呼吸机的病人,其中的一些病人死于潜在的致命性肺炎――而肺炎来自呼吸机本身。这个问题并非斯坦福大学医院独有。在美国,每年大约影响到6万人,超过50万病人存在风险――这个问题使病人的花费超过4万美元。
通过斯坦福大学生物设计培训计划(Stanford Biodesign),费伊和另外4个同学在医院观察了6周,发现了大约350个有待满足或改进的临床需求问题。而作为一名受过严格训练的生物医学工程师,费伊发现致命性肺炎“特别引人注目”。他说:“显然,戴呼吸机的都是危重患者,正在死亡线上挣扎,医护人吊有责任保证他们的安全。”
Stanford Biodesign计划是为博士、工程师、临床医生开设的一门“生物医学科学中的企业家精神”速修课。通过10个月的学习,旨在培养学员运用市场的方法化解存在的问题。一些学员根据课程实习不仅提高了解决问题的方法,甚至成功创办了自己的公司。
“要想让你的研究有价值,最好的方法就是做正确的事;而正确的事是从了解需求是什么开始的”。Stanford Biodesign计划的设计者、波士顿科学公司负责神经调节事务的研发工程师罗斯·维努克(Ross Venook)如是说。下面是发现临床问题和检验你的市场可行性方案的一些技巧,这对任何药企来说,也是两个必须的步骤。
善于发现需求
学会识别 费伊说:“通常科学界存在着这么一种趋向,即把观察误认为是一种需求。”但观察问题仅仅是应对这个问题的根源给出明确定义的第一步。例如,如果一个医生仔细地在为患者插导尿管,观察者可能会得出这样的结论:医生需要一根更好的导尿管。然而,这个例子中的“需要”就是一种更好的插导尿管的方式――这是一个用不同工具即可解决的问题。
重在积累 Stanford Biodesign和至少4个其他相关计划要求学员积累几百种需求,便于从中挖掘其潜在的项目。维努克说,这一过程要求学员“消化观察到的东西,并把它们转变成重要的临床需求”。
接触医生 作为Stanford Biodesign计划的一部分,学员们需要用时6——8周与临床医生交谈。维努克说:“为了做好转化工作,你应该和医生们在一起工作,我想这是非常关键的。”全面了解医院可能比较困难,但你可选择感兴趣的领域与医生接触,或看看相关的专业文献,然后作自我介绍。费伊说:“开始时你可能会被拒绝,但更多的是,你将会找到非常乐意与你交谈的人。”
走访实验室 费伊说,研究人员倾向于“喜爱”自己的专业技术,“而不是拿起你的综合技能,尝试着把它用于一切问题”。应该把思路放得更开阔,走访一些实验室,例如分子诊断学实验室,那里的研究人员从事的是一些特殊的测试工作。了解他们工作流程和使用的工具,能激发你解决问题或设计特定解决方案的创新潜能。费伊说:“找到能与你合作的人,说明你已经跨出解决问题的第一步。”
挖掘新闻 明尼苏达大学医疗器械中心的玛丽·约翰逊(Marie Johnson)认为,除了与医生交谈,从新闻报道中也能寻找到一些问题,“媒体像似一个侦探。”例如,保险公司近来宣布将停止为获得性感染患者支付费用的报道。这意味着医院将不得不支付这些费用,并将寻找能有效防止感染的产品。
再者,一些涉及药物或医疗器械及诊断学方面的负面新闻事件,或浏览医疗和保险公司的网站,然后再比对人们对这两个机构的呼吁和抱怨,细心的人从中也能抓住一些商机。
向专家求教 发现有待满足的需求的一个极好方法就是向专家咨询。例如,当你参加专业会议时,应主动与参会的专业技术人员探讨一些问题。毕业于戴维斯加州大学的萨马拉·弗里曼(Samara Freeman)说:“很多公司倾向于从学术界找到解决问题的方案。”包括一些临床医生经常意识不到其工作中存在的问题,往往采用一种不完善的程序完成工作。布伦达·琼斯(Brenda Jones)说,为了识别这种“隐性”需求,应多倾听临床医生讲述他们的工作经历和困惑。
“需求”清单 在网上,从事食品生产的通用磨坊公司(General Mills)详述了他们的一些特殊需求,你可以直接从网上寻找创新机遇。例如,网站上有这么一个需求:有一种食品在加工过程中需要“脱盐”,而找到一种替代品将是一种可能的解决方案。最近,这个公司已有38项类似需求在“通用磨坊全球创新网”上公布。
市场的可行性
做正确的事 下一步的工作就是落实你的需求清单。不幸的是,“这更多的是一门艺术,而不是科学。”费伊说。从头脑风暴的方法开始,剔除那些不能激起创意的解决方案,然后估摸其潜在的市场规模。第一步“你只需粗略估计。”例如,费伊的团队将市场拆分成“小型、中型或大型”,在所有情况相同时,将首先选择能达到最大化需求的市场。
PubMed搜索 这不仅仅是寻找想购买某一产品的群体,而是需要有足够的顾客购买;若想了解市场规模的大小,首先必须确定该产品能否解决问题。在美国国家医学图书馆的PubMed数据库查询系统搜索关于流行病学研究的文献资料,就能了解到全国范围内医院报告的统计资料。仅充血性心力衰竭的治疗费用,每年超过380亿美元。该病影响着大约10%的75岁以上的老人。“你不可能仅仅为一个人而设计,”约翰逊说。
至少值5亿 除了疾病的普遍性和发生率数据,“美国保健费用与利用计划”(HCUP)数据库还提供成本估算。把这些成本乘以认可的产品设计方案,你就能估算出每年在某一产品上所得到的回报。约翰逊说,从一个风险投资者的立场来看,你的产品必须值“5亿美元或更多”。一个可行的产品应该有市场,如果它能解决一个“昂贵”的问题,那么它就更有价值。
“20个法则” 据戴维斯加州大学负责商业发展项目的安德鲁·哈格顿(Andrew Hargadon)回忆,在一次培训的最后阶段,学员们打电话以了解客户的想法,从中发现了一种廉价测定血液中不同类型维生素D的方法。当学员给一个医生打电话时,他的第一反应是“相当有趣”;而第二反应是“你知道,我从不那样做。”因为维生素D非常便宜,医生宁愿开一种补充维生素D药物也不愿去费力做试验。哈格顿说,这就是“20个法则”,你“直到与至少20个告诉你‘那正是我一直在寻找的’的客户交谈后,才能开始你的事业”。
应对策略 如果在美国专利商标局网站上发现了与你的产品类似的东西,也不意味着你该放弃这个创意,但可能会影响你的销售方式。约翰逊认为,你可以通过支付专利许可费来克服这种影响,或者,尝试与开发类似产品的公司联系,看看他们是否有兴趣购买你的创意。“你必须意识到,当地的技术转让部门可能对你的创意有所帮助。
资料来源 The Scientist
责任编辑 则 鸣